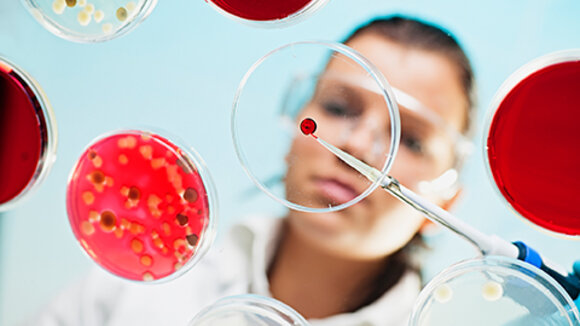
Mikroben, Pilze und Enzyme machen vor, wie biologische Systeme Plastik nicht nur abbauen – sondern in Rohstoffe, Habitate und sogar Medikamente verwandeln.

Bericht
Mikroben machen aus Plastik neue Wertstoffe
Es gibt verschiedene Methoden, gebrauchtes Plastik sinnvoll zu verwerten. Ein weiterer Ansatz ist der Einsatz von Mikroben, Pilzen und Enzymen: Sie bauen Kunststoff nicht nur ab, sondern verwandeln ihn in nützliche Produkte – bis hin zu Medikamenten.